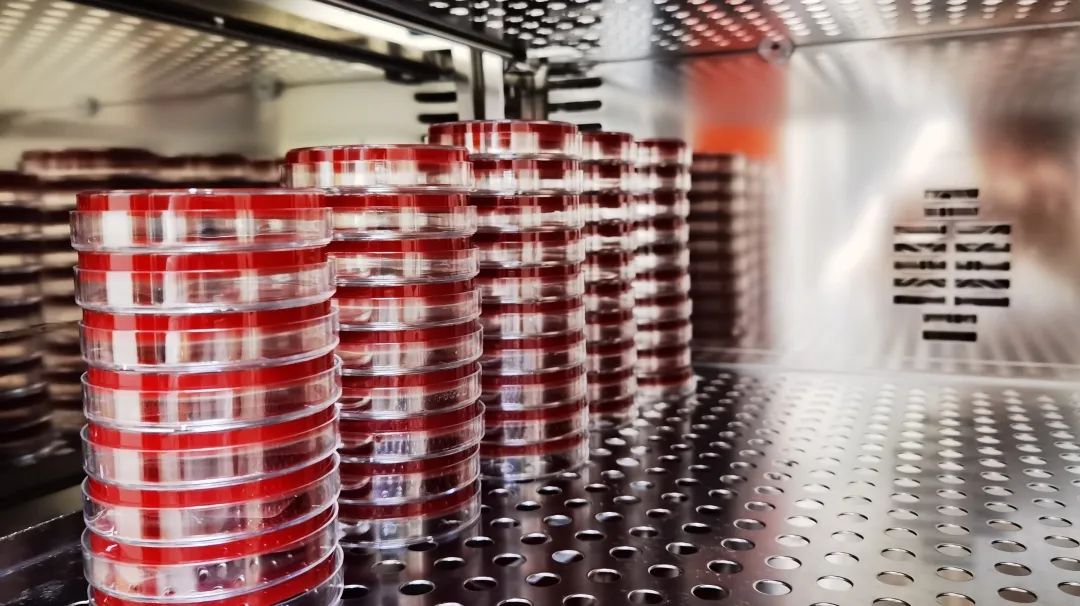
下腹痛白带水样,小腹疼白带多做什么检查

那就是宫颈分泌物培养
听起来有些陌生是不是?
但是在我们妇产科医院
这可是微生物最常见的检查项目之一
尤其是有小腹痛、白带脓性的女性
这是为啥呢?
那就要从一个致病菌说起了
你的宫颈是怎么生病的?
哈喽大家好,我是一个致病菌,家族成员有各种细菌和真菌,我喜欢待在透明的、温暖的宫颈粘液里。

本来健康的宫颈粘液里也有各种各样的菌,不过他们和我不同,他们是有益的健康菌,一起守护宫颈阴道微生态平衡,每次我想入侵,他们都要和我来一场大战。
但是如果人体免疫力下降,*生活性**紊乱、不洁,或者我的毒力较强,数量太多......那么就很容易进攻了。
一旦我得手,嘿嘿,微生态的平衡被打破,那么宫颈炎、细菌性阴道病、念珠菌感染......就要找上你了。
所以检查的作用,就是找到我,还要找到对我有效的药,我可恨死那些检验医生了。
不过我藏得很深,要找出我,过程堪比探案。
探案第一步: 取 样
因为各种菌群对生存环境的要求很高,我也不例外,如果采样不规范,送样不及时,嘿嘿,那医生可就找不到我了。

通常医生要把无菌拭子插入子宫颈口1-2cm,停留大约10s后才能把宫颈粘液取出来,有些患者可能会有轻微的不适感。常温下2小时内就要把我送到微生物实验室,不然我就会死掉。
探案第二步: 接 种
到达微生物室后,医生第一步要做的是核实检查项目并进行接种。所谓接种就是使用分区划线法,把宫颈粘液接种于哥伦比亚血平板培养基,随后就送进35℃的孵箱内。
这可是细菌和真菌生长的好环境啊,兄弟们,疯狂生长吧!
通常48小时内,若没有菌落生长,医生们就会发出阴性报告。当48小时内长出菌落时,就要当心了,这其中可能就有我的兄弟姐妹。
探案第三步: 找出致病菌
当发现血平板上长出菌时,医生就会观察菌落的形态、挑取菌落进行涂片染色和显微镜镜检,看看是有益的菌,还是有害的菌?
细菌和人类一样,不同的细菌形成的菌落大小、颜色、气味、形态、生化反应都是不同的。
微生物室的医生会制作特殊的“细菌片”,然后经过一系列的染色处理,最后在显微镜下观察,从而做出初步的判断。到了这一步我想逃都逃不掉了。

各种各样形状的菌,需要医生长期阅片的经验来判断
当生长的菌群主要为正常菌群,通常会在48小时后发出报告;当有异常时,医生们就能发现我,并且可以判断基本特征。
接下来就要纯分了,就是把我从一堆菌群中单独拎出来“拷打”。
医生们会用接种环把我挑出来,接种在血平板或真菌显色平板,然后置于35℃孵箱培养。哎,我太迷恋这个环境了,24小时后不得不现出原形,他们就能获得单个菌落了。
然而,这一切还木有结束,他们非要把我的户口查得清清楚楚。
探案第四步: 质谱分析仪来鉴定菌种
这一步的原理简单来说是,他们会把我“按”在一个靶板上,然后通过激光激发我和基质,让我身上最有个性的蛋白质在真空飞行管中飞行,然后通过飞行时间来鉴定我的真实姓名。

此时,我姓谁名啥,体貌特征,他们都搞得清清楚楚。
哎,始终逃不出他们的手掌心啊。
探案第五步: 找出“灭菌”的药
接下来,他们就要对我公开处刑了。但是药物那么多,我可不是每一种都怕的。最怕他们用上了药敏试验,那就离找到“杀菌药物”不远了。

对于常见的细菌兄弟,全自动药敏仪一波操作之后,等待24小时就能得到准确的药敏结果。
对于真菌大哥呢,一般放置24小时后也可看到药敏结果,而一些生长较慢的兄弟,如光滑念珠菌等,可能需要放置48小时后才能观察结果。
找到了敏感的药,就能马上消灭我吗?
真是太天真了,我才不会被轻易*倒打**。机器也有不靠谱的时候。
探案第六步: 找到的药靠谱吗?
给我发布死刑通知书(药敏报告)前,医生们会判读之前的药敏结果是否可靠。他们真是不给我最后一点机会。
当医生们对药敏上机结果存疑时,会通过手工药敏纸片法进行复验,确保药敏结果的准确性。还会将各种特殊的耐药机制、一些细菌天然耐药特性等关键信息通过“专家评语”的方式体现在报告单中,从而提示临床医生选择性用药。
这哪里是药敏报告呀,分明是“要命”报告。

不过你最终用的是不是这个药?还得再看临床医生的经验。这千辛万苦得来的报告,是给临床医生们最靠谱的参考。
而到这为止,我基本上已经被分析得清清楚楚、明明白白,大去之日不远已。
不过,我最喜欢“心大”的病人。如果你觉得症状好了就不用药了,那么我告诉你,我马上又会卷土重来,哈哈哈哈。


撰文:陆娄恺奕、李妙然
图片:陆娄恺奕、彭怡倩
审核:高晶、陈丽梅
编辑:李妙然